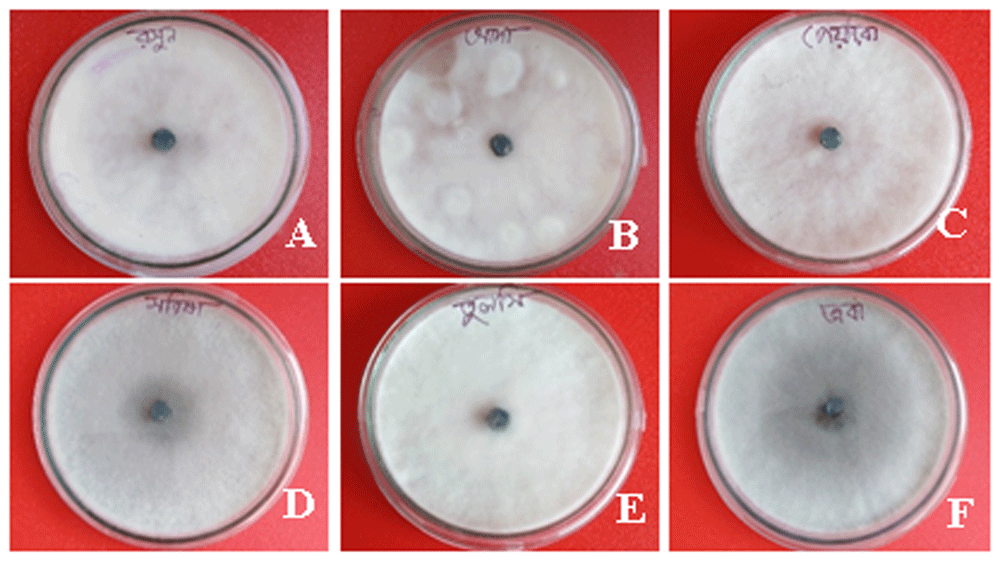
aa2fd04d-a75c-49bd-ad10-2818a8eef942_figure2.gif
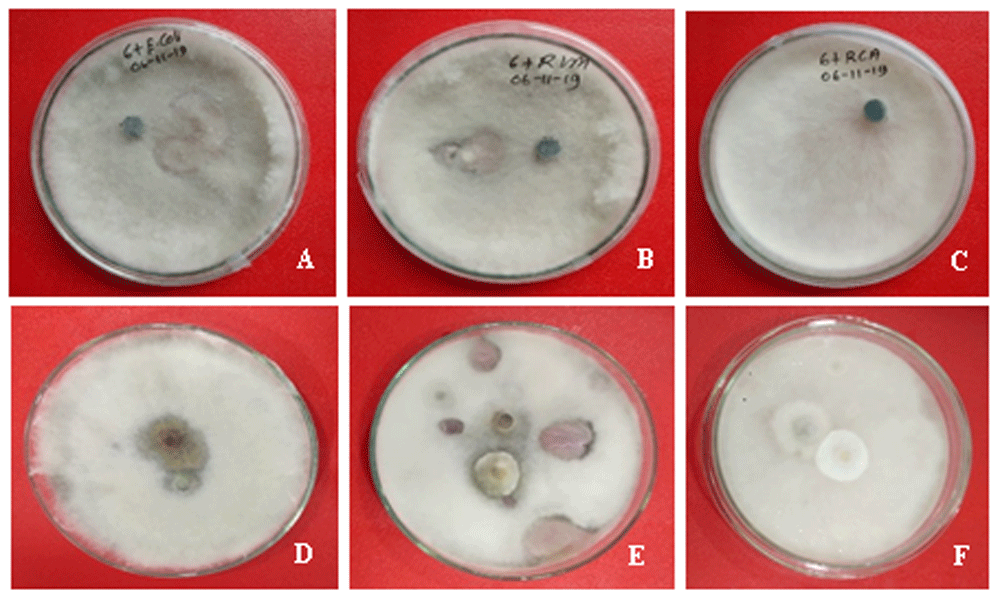
aa2fd04d-a75c-49bd-ad10-2818a8eef942_figure3.gif

Keywords
Fusarium sp., Plants extract, Non-pathogenic microbes, Antagonisms, Biocontrol
This article is included in the Agriculture, Food and Nutrition gateway.
This article is included in the Plant Science gateway.
Fusarium sp., Plants extract, Non-pathogenic microbes, Antagonisms, Biocontrol
Fusarium species are a large genus of hyaline filamentous mold fungi, responsible for fruit and vegetable crop rot (Al-Najada & Gherbawy, 2015; Ziedan et al., 2018). Fusarium species are deeply invasive and can cause hematogenously disseminated infections with high mortality in neutropenic patients (Dignani & Anaissie, 2004). Numerous species of Fusarium contribute to yield loss and reduced quality to varying degrees by infection with some mycotoxins (O’Donnell et al., 2009). They also cause decay of various fruit in storage and postharvest conditions (Whiteside et al., 1988). The fruit rot caused by Fusarium incurs enormous yield losses and is often observed in fields and markets (Baria et al., 2015). The application of antagonistic agents and plant extracts in agriculture are becoming a major focus of plant protection research. Different preservatives or fungicide treatments are frequently applied to manage fruits diseases and decay, which is an alarming health concern (Munhuweyi et al., 2020). Since most chemical fungicides are highly toxic to humans and animals and they frequently cause water and soil pollution (Al-Najada & Gherbawy, 2015). Moreover, continuous and indiscriminate use is leading to the development of fungicide resistant strains of pathogens (Tafinta et al., 2013).
In Bangladesh, fruit rot is a destructive disease caused by Fusarium species on pre-harvest and postharvest fruits. To the best of our knowledge, there is no previous research on biological control of this pathogenic fungus. Therefore, the main objective of the study was to find an ecofriendly control system of Fusarium sp., to decrease fruit and vegetable rot in Bangladesh.
A pure culture of Fusarium sp. was previously isolated and identified (Accession No. MT856371) from postharvest Citrus reticulata fruit rot (Hasan et al., 2020). The culture was preserved at the Department of Genetic Engineering and Biotechnology, University of Rajshahi (Rajshahi, Bangladesh).
For antifungal activities screening, six healthy, mature medicinal plants, Allium sativum, Zingiber officinale, Coccinia grandis, Brassica juncea, Ocimum tenuiflorum and Hibiscus rosa-sinensis were collected from Mirzapur, Binodpur and Kajla village, Motihar, Rajshahi, Bangladesh.
Collected plants were washed with water to remove dust from the plants’ surface and dried in room temperature. Plant extract preparation and fractionation was performed according to the method by Kader et al. (2018). Different parts of selected plants (bulb of Allium sativum; rhizome of Zingiber officinale; leaves of Coccinia grandis, Brassica juncea, Ocimum tenuiflorum; and flowers of Hibiscus rosa-sinensis plants) were cut into small species and ground by blender to form fine powder. The dried powder of the plants (100gm of each plant) were rinsed in methanol (500ml) using a conical flask, and were incubated in a shaking incubator with occasional shaking for fourteen days. The liquid contents were pressed through Markin cloth followed by filtration using Whatman no. 1 filter paper. Obtained filtered liquids were dehydrated in vacuo to leave a blackish and sticky mass. The extracts were collected in vials and preserved in a refrigerator at 4°C.
The inhibitory effect of different plant extracts was measured by following the poisoned food technique (Balamurugan, 2014). For this, 20µg of each plant extract was added to 20ml of potato dextrose agar (PDA) to fill a 90mm size Petri plate and mixed well. After solidification, seven day old 6 mm size fungal plug was placed in the center of the Petri plates. The Petri plates were incubated at 35°C for seven days in static condition.
For evaluation of antagonistic effects, six non-pathogenic pure microbe cultures, Escherichia coli, Rhizobium phaseoli, Rhizobium leguminosarum, Neofusicoccum mangifera, Trichoderma viride and Pestalotiopsis sp. were used against Fusarium species. The pure microbe cultures were kindly provided by Dr. Md. Salah Uddin, Associate Professor and Director, Microbiology Lab., Department of Genetic Engineering and Biotechnology, University of Rajshahi, as the part of a collaboration.
To assess the antagonistic effects, the dual culture technique was used, as previously described (Vethavalli & Sudha, 2012). A mycelial disc of 6 mm diameter was cut from the periphery of both antagonist cultures and the test pathogen and placed on a Petri plate with PDA media. For the control, only the test pathogen was placed in the centre of a Petri plate. The Petri plates were incubated at 35°C in darkness.
The inhibition percentage of mycelial growth= [(Gc-Gt)/Gc] × 100; Where, Gc = Mycelial growth in terms of colony diameter in control set, Gt= Mycelial growth in terms of colony diameter in treatment set. The inhibition percentages of Fusarium species growth were calculated using the following formula: Inhibition percentage (%) =100× (dc– dt)/dc; Where, dc = radial growth of pathogen in control, dt = radial growth of pathogen in dual culture. Mean values were compared through least significant different test using SAS software, version 9.4M5 (SAS Inc., Cary, NC, USA). All the experiment and test were replicated thrice.
All plant extracts showed a degree of growth inhibition of the tested fungus at the same concentrations. The highest inhibition of growth of the isolates was observed at 68.1% of mycelium on Coccinia grandis, which was followed by 64.1% on Allium sativum, in comparison to the control culture (100.0%). Hibiscus rosa-sinensis showed the lowest inhibition of mycelium with 29.6% against the fungal isolate in comparison to the control. The results are presented in Figure 1 and Figure 2.

Mycelia were collected after seven days of incubation on potato dextrose agar at 35°C in darkness. 90 mm Petri plates were used to culture the tested fungus.
(A) Allium sativum, (B) Zingiber officinale, (C) Coccinia grandis, (D) Brassica juncea, (E) Ocimum tenuiflorum, and (F) Hibiscus rosa-sinensis. Mycelia were collected after seven days of incubation on potato dextrose agar at 35°C in darkness.
The highest percentage inhibition of radial growth was observed with Trichoderma viride (46.01%) against Fusarium, which was followed by 43.33% and 32.05% on Escherichia coli and Rhizobium phaseoli, respectively (Figure 3). The antagonistic agent Rhizobium leguminosarum did not show any inhibitory activity against the isolated fungus (Figure 3). The control group also did not show any inhibition of radial growth of Fusarium sp.
(A) Escherichia coli, (B) Rhizobium phaseoli, (C) Rhizobium leguminosarum,(D) Neofusicoccum mangifera, and (E) Trichoderma viride and (F) Pestalotiopsis sp., Mycelia were collected after seven days of incubation on potato dextrose agar at 35°C in darkness.
Fruit rot caused by Fusarium species is very common in Bangladesh. The main objective of the present study was to study biological control measures for this fungus. Plant extracts are now a superior choice to control different plant pathogens, as reported by several previous studies (Hasan et al., 2020; Kareem & Al-Araji, 2017; Parveen et al., 2014). In our study, we found that the plant extracts Allium sativum, Zingiber officinale, and Coccinia grandis have significant inhibitory effects on mycelial growth of Fusarium species. Hosen & Shamsi (2019) also found significant antifungal activity using Allium sativum (53.85%), Ocimum sanctum (48.72%) and Zingiber officinale (49.35%) against Fusarium solani and F. oxysporum. Our current results were also supported by data from Khatun et al. (2020) and Kareem & Al-Araji (2017). Confirmation of the potential of antagonists on the radial growth of the pathogen in dual culture have been previously reported by Akhtar et al. (2010). By contrast, Nasrin et al. (2018) reported 87% inhibition potency on mycelium growth of Fusarium oxysporum f. sp. lycopersici by Calotropis proceraon plant extract. In our study, Trichoderma viride, Escherichia coli, Rhizobium phaseoli and Alternaria sp. showed significant antagonistic activity against Fusarium species. Trichoderma viride showed 45.88% growth inhibition on Fusarium merismoides fungi in a study by Hosen & Shamsi (2019), which support our present findings. Nasrin et al. (2018) also reported 82% inhibition radial growth by Trichoderma sp. against Fusarium oxysporum f. sp. lycopersici. In contrast, Bashar & Chakma (2014) reported that volatile substances produced by T. viride, A. niger, A. flavus and A. fumigatus showed 29.75, 20.15, 15.78 and 12.25% growth inhibition, respectively, on F. oxysporum.
In the current investigation, there are some limitations. Although this study showed that some plant extracts and nonpathogenic microbes could control the fungal stain, the number of plant extracts and microbes was limited. In addition, we used only methanol solvent for extraction and did not use other extractions. Moreover, we performed only in vitro techniques for antifungal potency screening and did not use any in vivo techniques. Therefore, we need to perform further studies to detect ecofriendly control this devastating fungal stain in the future.
We evaluated different biological control measures for the devastating Fusarium fungi. Various medicinal plant extracts and non-pathogenic microbes showed promising inhibitory activities on Fusarium sp. in vitro. These identified control measures of Fusarium species show the importance of further research on Fusarium taxonomy to decline the risk of Fusarium-caused fruit rot in Bangladesh.
Figshare: Effect of plant extracts on inhibition of mycelial growth of the Fusarium species. https://doi.org/10.6084/m9.figshare.13096262 (Hasan, 2020a). This project contains the images of Petri plates for each treatment condition.
Figshare: Effect of antagonistic agents on inhibition of mycelial growth of the Fusarium species. https://doi.org/10.6084/m9.figshare.13096325 (Hasan, 2020b). This project contains the images of Petri plates for each treatment condition.
Figshare: Effects of different plants extract by methanol on inhibition percentages of mycelial growth of the Fusarium species, https://doi.org/10.6084/m9.figshare.13134953 (Hasan, 2020c).
Figshare: Effect of antagonistic agents on inhibition of mycelial growth of the Fusarium species, https://doi.org/10.6084/m9.figshare.13134962 (Hasan, 2020d).
Data are available under the terms of the Creative Commons Attribution 4.0 International license (CC-BY 4.0).
A previous version of this article is available on Figshare: https://doi.org/10.6084/m9.figshare.13012517 (Hasan, 2020e).
| Views | Downloads | |
|---|---|---|
| F1000Research | - | - |
|
PubMed Central
Data from PMC are received and updated monthly.
|
- | - |
Is the work clearly and accurately presented and does it cite the current literature?
Yes
Is the study design appropriate and is the work technically sound?
Yes
Are sufficient details of methods and analysis provided to allow replication by others?
Partly
If applicable, is the statistical analysis and its interpretation appropriate?
No
Are all the source data underlying the results available to ensure full reproducibility?
Partly
Are the conclusions drawn adequately supported by the results?
Yes
Competing Interests: No competing interests were disclosed.
Reviewer Expertise: Microbiology, Ecology, Nanotechnology, Phytochemistry, Fermentation technology
Is the work clearly and accurately presented and does it cite the current literature?
Yes
Is the study design appropriate and is the work technically sound?
Yes
Are sufficient details of methods and analysis provided to allow replication by others?
Yes
If applicable, is the statistical analysis and its interpretation appropriate?
Yes
Are all the source data underlying the results available to ensure full reproducibility?
Yes
Are the conclusions drawn adequately supported by the results?
Yes
Competing Interests: No competing interests were disclosed.
Reviewer Expertise: Pharmacological evaluation of ethnomedicinal plants, natural products chemistry and drug discovery
Is the work clearly and accurately presented and does it cite the current literature?
Yes
Is the study design appropriate and is the work technically sound?
Partly
Are sufficient details of methods and analysis provided to allow replication by others?
Partly
If applicable, is the statistical analysis and its interpretation appropriate?
Yes
Are all the source data underlying the results available to ensure full reproducibility?
Yes
Are the conclusions drawn adequately supported by the results?
Yes
Competing Interests: No competing interests were disclosed.
Reviewer Expertise: Microbial Diversity, Plant-Microbe interaction, Phytoremediation
Alongside their report, reviewers assign a status to the article:
| Invited Reviewers | |||
|---|---|---|---|
| 1 | 2 | 3 | |
|
Version 2 (revision) 27 Apr 22 |
read | ||
|
Version 1 03 Dec 20 |
read | read | read |
Provide sufficient details of any financial or non-financial competing interests to enable users to assess whether your comments might lead a reasonable person to question your impartiality. Consider the following examples, but note that this is not an exhaustive list:
Sign up for content alerts and receive a weekly or monthly email with all newly published articles
Already registered? Sign in
The email address should be the one you originally registered with F1000.
You registered with F1000 via Google, so we cannot reset your password.
To sign in, please click here.
If you still need help with your Google account password, please click here.
You registered with F1000 via Facebook, so we cannot reset your password.
To sign in, please click here.
If you still need help with your Facebook account password, please click here.
If your email address is registered with us, we will email you instructions to reset your password.
If you think you should have received this email but it has not arrived, please check your spam filters and/or contact for further assistance.
Comments on this article Comments (0)